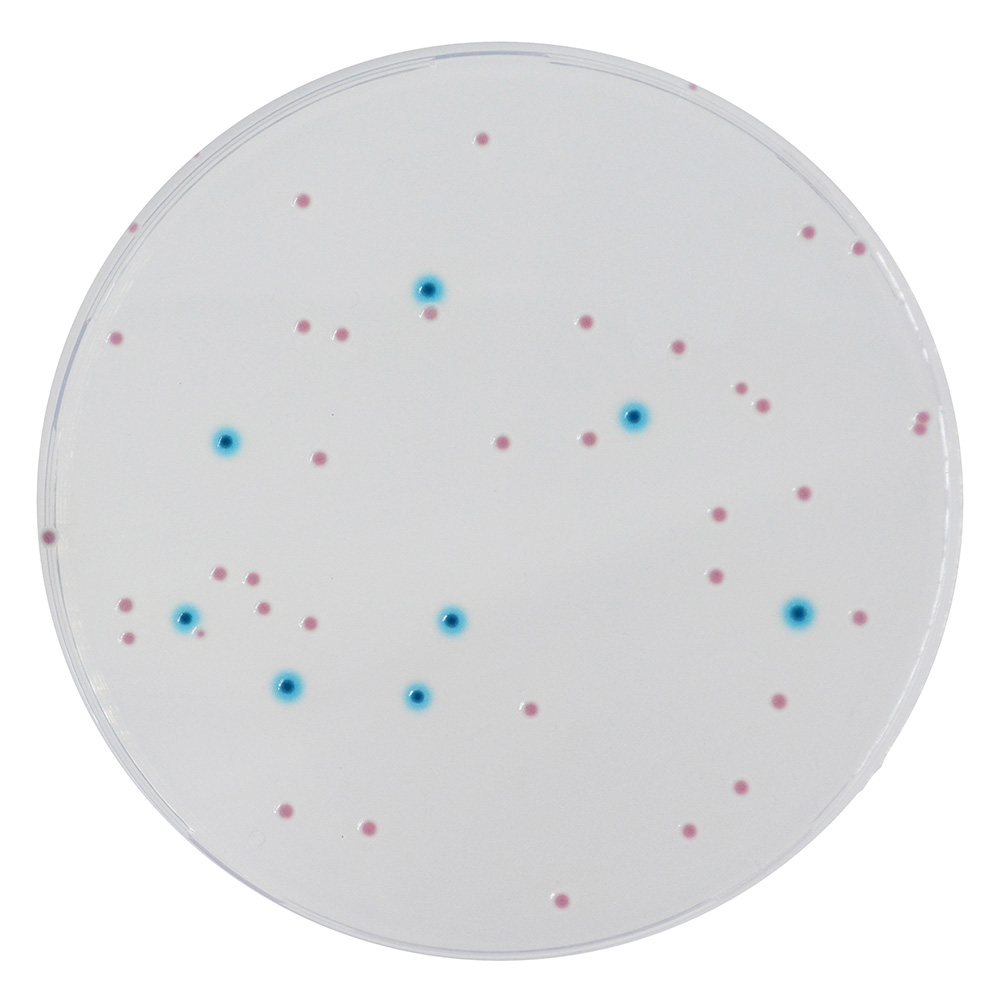

Über das Produkt
Chromogenes Medium zur Detektion und Zählung von Enterobacterales.
Ähnliche Produkte
CHROMagar E.coli Fertigplatten (ohne CE)
CHROMagar E.coli O157 Fertigplatten (ohne CE)
CHROMagar STEC Fertigplatten
CHROMagar Enterobacteria (5L) - ohne CE